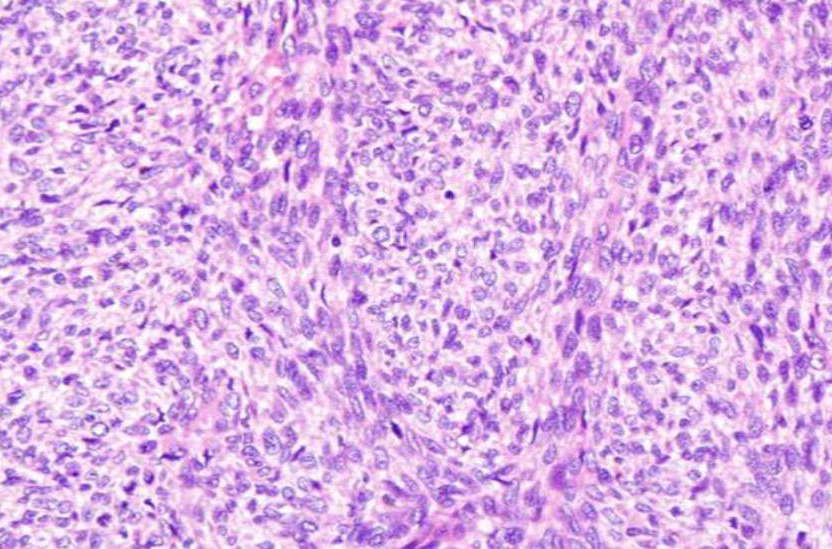
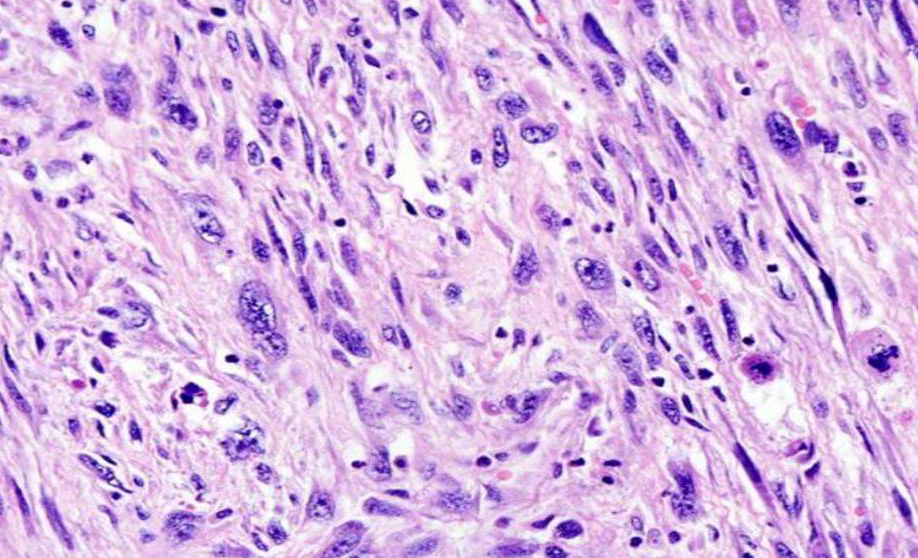

![]()

口腔癌是指发生于口腔黏膜的鳞状细胞癌(squamouscell carcinoma),它是具有不同程度鳞状分化的上皮性侵袭性的肿瘤,有早期广泛淋巴结转移的倾向,且主要发生在40~60岁的烟酒嗜好者。口腔癌约占口腔恶性肿瘤的90%。流行病学资料显示,2000年,全球发生口咽癌389 650例,其中口腔266 672例,口咽部122 978例。该数字占男性癌症的5%和女性的2%。我国七所口腔医学院病理资料中,口腔鳞癌21 964,占31.4%。
口腔癌确切的发病原因仍不十分明了。现在的研究表明,口腔癌主要的危险因素是吸烟和酗酒,烟酒之间具有很强的协同作用。在欧洲、美洲和日本,75% 口腔和口咽癌的患者有烟酒嗜好,不饮酒的吸烟患者的危险性较不吸烟的饮酒者明显增长。无烟烟草是印度次大陆、东南亚、中国台湾省以及有这些国家移民的国家口腔和口咽鳞状细胞癌的主要原因,尤其是用含槟榔壳和氢氧化钙的烟。
人类乳头瘤病毒16和18在口腔癌中有不同的发现。目前研究表明,人类乳头瘤病毒是一小部分口腔癌和40% 以上的口咽癌的病因学因素。
【临床表现】
口腔癌早期经常是无症状或症状不明显,因此对小病损的诊断,尤其当患者有烟酒嗜好的时候更应注意。患者可能出现红色病损、红白相间的病损或者白色病损。和白斑共存的时候经常会发现癌,虽然在不同的人群中变化很大,但仍意味与白色病损有一定的关系。口腔癌的表现根据口内部位的不同而有所变化。黏膜增生和溃疡、疼痛、耳部的牵涉性疼痛、口臭,语言、张口和咀嚼困难、吞咽困难和疼痛以及出血、消瘦、颈部肿大是常见的口腔癌晚期的症状。 由于口腔黏膜与颌骨邻近,因此口腔癌易侵犯骨,特别是累及下颌管时,除神经症状外,无明显表现。
【病理变化】
【鳞状细胞癌】
鳞状细胞癌肉眼观常呈菜花状,也可坏死脱落而形成溃疡。癌组组也同时向深层作浸润性生长。镜下见在分化好的鳞状细胞癌的癌中,细胞间还可见到细胞间桥,在癌巢的中央可出现层状角化物,称为角化珠(keratin pearl)或癌珠。分化较差的鳞状细胞癌无角化珠形成,甚至也无细胞间桥,瘤细胞呈明显的异型性并见较多的核分裂像。浸润性癌细胞呈实性片块状、条索或岛状甚至为单个癌细胞浸润。如果癌细胞浸润范围较表浅仅限于基底膜下方时可称为微浸润性鳞状细胞癌(microinvasion squamous cell carcinoma)。为了预测鳞状细胞癌的侵袭性,估计其预后和选择有效的治疗方法,常常对鳞状细胞癌进行分级。世界卫生组织(WHO,2005)根据肿瘤的恶性程度、细胞和细胞核的多形性以及细胞分裂活性等将口腔鳞癌分为高、中、低分化三级:

◇ 高分化鳞癌与正常鳞状上皮颇类似,即含有数量不等的基底细胞和具有细胞间桥的鳞状细胞,角化明显,核分裂象少,非典型核分裂和多核细胞极少,胞核和细胞多形性不明显。
◇ 中度分化鳞状细胞癌具有独特的核的多形性和核分裂,包括非正常核分裂,角化不常见,细胞间桥不明显。
◇ 低分化鳞癌以不成熟的细胞为主,有大量的正常或不正常的核分裂,角化非常少,细胞间桥几乎不能发现。
尽管角化出现在高或中分化鳞癌中,但并不能作为鳞癌分级的重要组织学标准。超过90%的口腔癌、口咽癌为Ⅱ级分类。口腔鳞癌分级对判断治疗效果或反应方面作用有限,因组织分级自身存在不足,如评价组织和细胞学特征方面存在主观性;肿瘤组织存在异质性,小块活检组织难以判断病变全貌;组织固定和保存不良;评价的依据仅是瘤细胞的结构特征而不是功能特征;而且在评价癌细胞特征时,未对其周围支持组织评价等。因此,Bryne等提出的口腔癌浸润前沿学说(invasive-front hypotheses)或称肿瘤浸润前沿(invasivetumour front,ITF)受到重视。ITF是指位于肿瘤-宿主交界处最前沿的3-6层肿瘤细胞或分散的细胞团,涉及的内容主要有口腔癌的异质性(heterogeneity),浸润前沿的组织病理分级、分子病理学以及肿瘤细胞和肿瘤间质细胞之间相互作用等。对肿瘤浸润前沿进行组织学分级,在预测淋巴结转移、局部复发、生存率方面的价值显著高于传统的肿瘤的组织学分级。
目前的研究显示,一些临床病理指标在预测口腔癌的预后中具有一定价值。通常位于口腔后部的口腔癌患者5年生存率较低,下唇癌患者5年生存率约为90%,舌前部肿瘤为60% ,发生于舌后部、口底、扁桃体、牙龈和硬腭部者为40%,软腭癌为20%一3O%。主要是由于不同部位的肿瘤,淋巴结转移率不同。如牙龈肿瘤淋巴结转移率低于7%,颊部肿瘤为22%,而舌、磨牙后区、口咽部肿瘤的淋巴结转移率为59-64%。肿瘤厚度(即肿瘤侵袭深度)具有独立预后价值,也是颈淋巴结转移的高发因素。肿瘤手术切缘状况与肿瘤复发、患者生存率相关,但安全手术切缘的界定标准尚有待统一。有研究提出,颈淋巴结转移状态是影响口腔鳞癌预后的最重要因素,而颈淋巴结包膜外扩散是影响口腔癌预后的重要原因。OSCC转移淋巴结主要分布于Ⅰ、Ⅱ、Ⅲ区,同时跳跃性转移(即转移性淋巴结直接到Ⅳ区,而Ⅰ-Ⅲ区淋巴结为阴性)也是口腔鳞癌中不可忽视的现象。口腔癌的临床分期、颈淋巴结状态、转移颈淋巴结累及区域数、转移颈淋巴结最低累及区域与患者预后有关,而转移淋巴结大小、数目对患者预后无明显影响。肿瘤是否有淋巴结转移、淋巴结转移程度特别是肿瘤的淋巴结包膜外浸润在预测肿瘤复发、远处转移、生存率方面具有重要意义。肿瘤的临床分期是重要的肿瘤预后因素,其意义显著大于肿瘤组织学分级。肿瘤的血管、淋巴管及神经侵犯也是有用的预后因素。
----------------------------------------------------------------------------------------
【疣状癌】
 疣状癌(verrucous carcinoma)1948年首先由Ackerman作为一型独立的肿瘤加以描述。现已明确为一种非转移性的高分化鳞癌的亚型,以外生性、疣状缓慢生长和边缘推压为特征。长期使用烟草可能是口腔疣状癌的主要病因学因素。人类乳头瘤病毒亚型16和18感染占口腔疣状癌的40%。
疣状癌(verrucous carcinoma)1948年首先由Ackerman作为一型独立的肿瘤加以描述。现已明确为一种非转移性的高分化鳞癌的亚型,以外生性、疣状缓慢生长和边缘推压为特征。长期使用烟草可能是口腔疣状癌的主要病因学因素。人类乳头瘤病毒亚型16和18感染占口腔疣状癌的40%。
疣状癌以老年男性多见,75%的疣状癌发生在口腔,其中以下唇多见,颊、舌背、牙龈、牙糟黏膜均可发生。病变开始时为边界清楚、细的白色角化斑块,迅速变厚,发展成钝的乳头状或疣状,表面突起。此肿瘤通常表现为宽的基底或者无蒂,一般无症状,不出现溃疡和出血。
疣状癌由厚的棒状乳头和具有明显角化的分化良好的鳞状上皮呈钝性突入间质内构成。鳞状上皮缺乏一般恶性肿瘤的细胞学改变,细胞较鳞状细胞癌中的细胞大,核分裂象少见,且仅位于基底层,有时可见上皮内微小脓肿。疣状癌呈推进式侵犯间质,无浸润边缘。密集的淋巴细胞、浆细胞是常见反应。癌周上皮下陷呈杯状包围在疣状癌的周边,这是进行深部活检的理想部位。
疣状癌中含有传统的鳞状细胞癌的病灶时则称为杂交瘤。约1/5的肿瘤与鳞状细胞癌共存。认识疣状癌的这种变异非常重要,因其具有更易局部复发和转移的潜能。目前,对于口腔疣状癌尚无分子或其他标志物具有预测性意义。
疣状癌的鉴别诊断包括外生性鳞状细胞癌、杂交瘤疣状癌、乳头状鳞癌、角化性鳞状细胞乳头状瘤和寻常疣。疣状癌以缓慢的局部侵袭性生长为特征,如不治疗,可引起局部广泛破坏。广泛的外科切除而不作颈清手术,5年无病存活率是80%~90%。单纯的疣状癌不转移。相反,杂交瘤疣状癌具有转移潜能。
----------------------------------------------------------------------------------------
【基底细胞样鳞状细胞癌】
 基底细胞样鳞状细胞癌(basaloid squamous cell carcinoma, BSCC)亦称基底样癌(basaloid carcinoma)、腺样囊样癌(adenoidcystic-like carcinoma),是一种侵袭性的、高级别的鳞状细胞癌的亚型,同时具有基底细胞样和鳞状细胞的成分。烟酒的滥用已被证实为强的危险因素。
基底细胞样鳞状细胞癌(basaloid squamous cell carcinoma, BSCC)亦称基底样癌(basaloid carcinoma)、腺样囊样癌(adenoidcystic-like carcinoma),是一种侵袭性的、高级别的鳞状细胞癌的亚型,同时具有基底细胞样和鳞状细胞的成分。烟酒的滥用已被证实为强的危险因素。
病变多发生在喉、咽下和舌根部,男女均可发病,但以60~80岁的男性为主。生长迅速,病变外观表现为中央溃疡性肿块,伴黏膜下广泛的硬结,常与小涎腺肿瘤或其他软组织肿瘤混淆。
肿瘤由基底样细胞和鳞状细胞两部分组成。基底样细胞小,核浓染,没有核仁,胞质少,排列紧密,分叶状实性排列。在一些病例中小叶周边细胞呈栅栏状排列。多见粉刺样坏死。基底细胞样鳞状细胞癌常伴有鳞状细胞癌的成分,鳞状细胞和基底样细胞间的分界可以非常突然。此外也可伴有梭形细胞成分。常需与神经内分泌癌、腺样囊性癌、腺鳞癌等相鉴别。
基底细胞样鳞状细胞癌的前驱细胞可能来源于表皮基底层或小涎腺近端导管的全能原始细胞。虽然还有争议,但一般认为在分期相同的情况下,较鳞状细胞癌更具有侵袭性。
----------------------------------------------------------------------------------------
【乳头状鳞状细胞癌】
乳头状鳞状细胞癌(papilary squamous cell carcinoma)是鳞状细胞癌的一个独特亚型,以外生性乳头状生长和预后良好为特征。主要发生于60~70岁的男性。烟酒的滥用是其致病因素,报道的人类乳头瘤病毒感染率的变化范围在0~48%之间。

乳头状鳞癌表现为柔软、质脆的、外生性、息肉样的肿瘤,常发自一个较细的蒂。肿瘤以显著的乳头状生长为特点,这些乳头有纤细的纤维血管轴心,表面覆以肿瘤性的、不成熟的基底样或多形性的细胞。常见坏死和出血。间质侵袭由单个或多个癌巢构成,在肿瘤-间质界面有大量的淋巴细胞浆细胞浸润。如未见间质浸润,则将病变称为非典型乳头状增生或原位乳头状癌。肿瘤可以转移至局部淋巴结,但很少有远处转移。虽然报道结果不一,但乳头状鳞癌的患者预后一般要比鳞状细胞癌患者好。
----------------------------------------------------------------------------------------
【梭形细胞癌】
梭形细胞癌(spindle cell carcinoma)是一种双相性肿瘤,由原位或侵袭性的鳞状细胞和恶性的梭形细胞构成(图19-26)。主要见于70岁左右的男性,与烟酒滥用有关,也可继发于辐射暴露后。常表现为不同大小的息肉样外观。表面常有溃疡。梭形细胞成分常构成肿瘤的大部分,有时只见梭形细胞,可被误认为真性肉瘤。肿瘤细胞可表达上皮和间叶两种标记。在40%~85%的病例中梭形细胞可表达细胞角蛋白。25%的病例转移至局部淋巴结,远处播散少见。据报道5年生存率为65%~95%。

----------------------------------------------------------------------------------------
【棘层松解性鳞状细胞癌】
棘层松解性鳞状细胞癌(acantholytic squamous cell carcinoma)也称腺样鳞状细胞癌(adenoid squamous cell carcinoma), 是鳞状细胞癌的一个少见的亚型,特征是肿瘤细胞的棘层松解、形成假的腔隙和假的腺管分化的外观。该肿瘤无特殊的临床特点,生物学行为与鳞状细胞癌相似,来源于表层的鳞状上皮。
----------------------------------------------------------------------------------------
【腺鳞癌】
腺鳞癌(adenosquamouscarcinoma)是罕见的来源于表层上皮的侵袭性肿瘤,由鳞状细胞癌和腺癌两种成分构成。好发于男性,多发生在60~70岁年龄。外观为外生性或息肉状的肿块,或边界不清的黏膜硬结,常有溃疡形成。鳞癌部分可以是原位癌或浸润癌,腺癌成分多见于肿瘤的深部,为腺结构,其衬里细胞为基底样细胞、柱状或产黏液细胞。腺鳞癌与高度恶性的黏液表皮样癌的区别是较困难的,前者的腺癌与鳞癌成分相互间较易分辨,而高度恶性黏液表皮样癌中主要为中间细胞,其中少见孤立性产黏液细胞。腺鳞癌还应与棘层松解性鳞状细胞癌相区别。腺鳞癌来源于表皮具有多向分化的基底细胞。据报道腺鳞癌比鳞状细胞癌更具有侵袭性,且75%的患者有局部淋巴结转移,25%的患者有远处转移,5年生存率15%~25%。

恶性黑色素瘤(malignant melanoma)是一种来源于黑色素细胞或黑色素前体细胞的恶性肿瘤。以位于上皮-结缔组织交界处的非典型黑色素细胞为特点,向上浸润至上皮内,向下侵犯结缔组织。虽然常见于皮肤,它也可源于黏膜的黑色素细胞。头颈部黏膜黑色素瘤占所有黑色素瘤的1%。,其中50%来于口腔。口腔黏膜的黑色素瘤罕见,占口腔恶性肿瘤的0.5%,占口腔活检的比例不超过0.01%。

【临床特点】
口腔黑色素瘤约80%开始于腭部、上颌牙槽或牙龈黏膜。其它部位有下颌牙龈、颊黏膜、口底和舌部。20~80岁均可发病,平均年龄为55岁;男女发病相近。发生于儿童罕见。肿瘤通常为无痛性,边界不规则;直径一般在1.5~100px大小,表面黑色或灰褐色,斑点或结节状。无色素者罕见。典型病损表现为多发或广泛的色素斑点伴结节性生长。单纯的斑片病损虽可见到,但结节型或表现为色素性龈瘤者占到50%以上。约1/3的病例可见溃疡,侵犯骨常见。许多报道证明结节性病变之前长期存在黑变病,病史可达10年。口腔病损较隐蔽,就诊时常为晚期,约75%的伴有淋巴结转移,50%有远处转移,通常转移至肺部或肝脏。
【病理变化】
口腔黑色素瘤可分为原位和呈侵袭性生长期,但组织学分类与皮肤病损的分类不相同。黏膜的黑色素瘤与皮肤的肢端雀斑样黑色素瘤相似,具有交界活性,向表面侵犯,但Pagetoid侵犯不常见。非典型黑色素细胞病变可以进展成恶性黑色素瘤,但没有口腔黏膜良性色素痣发展成侵袭性恶性黑色素瘤的证据。因此,口腔黑色素瘤可分为原位口腔黑色素瘤、侵袭性口腔黑色素瘤和混合型三类。交界性病损可以定为非典型性黑色素细胞增生。
多数病例就诊时表现为侵袭性或具有混合性特点,完全属原位病变不超过20%。口腔黑色素瘤通常由片状或岛状的上皮样黑色素细胞构成,排列成器官样或腺泡样,胞质染色浅,核大、核仁明显,有时呈浆细胞样。片状和束状梭形细胞也可见到,一般仅占肿瘤的小部分。偶尔,细胞可以主要或全部梭形。90%以上的病损含黑色素。
原位成分表现为非典型的痣细胞,单独存在或在上皮-结缔组织界面形成细胞巢。细胞向表面侵犯常见,但与浅表扩散型皮肤黑色素瘤相似的Pagetoid岛不常出现。此时侵袭性较难确定,但在固有层出现明显的恶性细胞时提示有侵袭性;出现比上皮细胞更大的细胞岛提示处于侵袭性生长阶段,但奇怪的是有丝分裂罕见。被覆上皮通常萎缩,超过一半的病例溃疡形成。
95%以上的病例S-100阳性,CK阴性。S-100虽然比较敏感,但不是特异性标记物。更特异标记物包括HMB-45、Melan-A或抗酪氨酸酶,这些标记物阳性率可达75%。
口腔黑色素瘤的预后不良,平均存活时间为2年,5年存活率20%左右。分期是存活的一种预测因素。而在局限性(Ⅰ期)黑色素瘤,存活时间为5年的比例不足50%。由于缺乏足够的研究资料,浸润深度(Breslow thickness and Clark*s levels)在口腔病损中的预后价值有限,并且口腔黑色素瘤大多数深度超过4mm。肿瘤侵犯血管、坏死、多形性细胞群和较大的年龄均属预后不良相关的因素。

纤维肉瘤(fibrosarcoma)是一种由成纤维细胞及其产生的数量不等的胶原构成的恶性肿瘤,典型病例有人字形或鲭鱼骨样结构。该瘤有成人型(adult)和婴儿型(infantile )之分。发生于婴儿和年幼儿童,罕见转移,预后明显较好,自然病程类似于纤维瘤病。
【临床表现】
口腔纤维肉瘤可见于颊、腭、唇、颌骨的骨外膜、骨内膜和牙周膜。纤维肉瘤可发生于任何年龄,但大多数在30~50岁,中位年龄45岁。发生在5岁以上者称为成人型纤维肉瘤。发生于新生儿和婴儿,年龄不超过5岁者称为婴儿型纤维肉瘤。成人型多见。
【病理变化】
肿瘤由梭形细胞构成。瘤细胞排列呈特征性的连绵束状结构,细胞束排列成角,类似V形臂章或鱼骨样或编席状结构。间质为较丰富的胶原纤维和网状纤维,分化差的纤维肉瘤,其细胞丰富、异形明显、核分裂象多见。肿瘤边界不清,常浸润至周围组织。纤维肉瘤通常只表达波形蛋白,而不表达结合蛋白、S-100蛋白或角蛋白。
预后因素与肿瘤分级,肿瘤大小和肿瘤与表面皮肤或黏膜的距离有关。局部复发率与肿瘤切除是否充分有关,复发率为12%~79%。纤维肉瘤易转移至肺和骨,尤其是中轴骨,罕见淋巴结转移。5年存活率为39%~54%。提示预后差的指标有:肿瘤级别高,细胞丰富,核分裂大于20/10个高倍视野,有坏死以及胶原含量少。

近10多年来,纤维组织细胞性分化的概念受到了挑战,现在认为这是一种定义不明确的组织细胞形态分化。因此,在WHO(2002)软组织肿瘤分类中,对恶性纤维组织细胞瘤作了较大的修改。
【临床表现】
恶性纤维组织细胞瘤可发生于任何年龄,但以中老年多见。男性多于女性。常发生在四肢、腹膜后以及头颈部。恶性纤维组织细胞瘤
肿瘤细胞异型性明显性纤维组织细胞瘤虽然主要发生在软组织,但也发生在骨。口腔各部以及上、下颌骨均有病例报告。主要表现为肿块进行性增大,可有疼痛和面瘫。
【病理变化】
恶性纤维组织细胞瘤的组织学变化范围很大,其主要成分是成纤维样细胞和组织细胞样细胞,伴有数量不等的单和多核巨细胞、黄色瘤细胞、未分化间充质细胞和各种炎性细胞。各种瘤细胞的核和胞浆变异很大,奇形怪状,构成多形性表现,有些区域梭形细胞排列以车轮状结构为主,其他病损中可以是黏液样带、巨细胞、急性炎性细胞、黄色瘤细胞和血管为主。电镜下,瘤细胞显示成纤维细胞、成肌纤维细胞、组织细胞和间充质细胞特点。免疫组化方面无特异性标记物。
恶性纤维组织细胞瘤的治疗以广泛手术切除为主,辅以放疗和化疗。5年存活率为20%~60%。口腔病损影响了进食,其预后更不利。复发率和转移率约为40%。


血管肉瘤(angiosarcoma)又称软组织血管肉瘤(angiosarcoma of soft tissue)是一种恶性肿瘤,肿瘤细胞在一定程度上具有正常内皮细胞的形态和功能特点。
【临床表现】
软组织血管肉瘤罕见,各年龄段的发病率分布均匀,高峰年龄60~70,但发生于儿童非常罕见。大多数病变位于下肢深层肌内,其次为上肢、躯干和头颈部。病损呈红斑或暗色斑块并可发展为结节或溃疡。肿瘤致死的原因常常是肿瘤的扩展而不是转血管肉瘤瘤细胞间形成腔隙,内含红细胞,瘤细胞有异型性移。
【病理变化】
肿瘤由异形程度不等的内皮细胞组成。非典型内皮细胞围成不规则、互相吻合的血管腔。内皮细胞较肥硕,呈梭形、立方形或不规则形。核有明显异型,核分裂象易见。分化良好的区域,血管腔明显,或呈裂隙,或扩张成窦状,内皮细胞扁平,但仍有异形,深染,核分裂少见。增生的内皮细胞可达数层,甚至阻塞管腔或呈乳头状突入腔内。分化差的区域,内皮细胞呈实性巢或弥漫性排列,血管腔不明显,内皮细胞异型明显,核分裂象多,瘤细胞可呈梭形似纤维肉瘤,也可呈上皮样,难以与癌区别。肿瘤常有明显坏死。免疫组化显示瘤细胞表达第八因子相关抗原、荆豆凝集素-1、CD31和CD34,而CD31则有相对高的特异性和敏感性,对任何类型血管肉瘤病例约有90%阳性。约1/3软组织血管肉瘤表达细胞角蛋白。
软组织血管肉瘤具有高度侵袭性。约1/5病例局部复发,约一半病例可能在诊断后1年内死于转移,转移首位是肺,其次为淋巴结、骨和软组织。

淋巴瘤(malignant lymphoma)是一组起源于淋巴结或其他淋巴组织的恶性肿瘤,可分为霍奇金淋巴瘤(Hodgkin lymphoma)和非霍奇金淋巴瘤 (non-Hodgkin lymphoma, NHL)两大类。霍奇金淋巴瘤主要为淋巴结的病损,原发于结外的罕见。口内出现时,常见于Waldeyer环,尤其是腭扁桃体。多数患者为局限性病损(Ⅰ/Ⅱ期),症状表现外慢性扁桃体炎或扁桃体肿大,伴有或不伴有颈部淋巴结肿大。口咽部,下颌牙槽嵴和上颌牙龈亦有报道。淋巴瘤中绝大多数为非霍奇金淋巴瘤,其中 85%以上的是成熟的B细胞肿瘤,而大B细胞淋巴瘤和滤泡性淋巴瘤,占所非霍奇金淋巴瘤的50%。现就口腔颌面部较常见或有某些特征的几种淋巴瘤简要介绍如下:
【弥漫性大B细胞淋巴瘤】
弥漫性大B细胞淋巴瘤(diffuse large B-cell lymphoma, DLBCL)是一类由大B淋巴样细胞构成的肿瘤,呈弥漫性生长模式,肿瘤细胞的胞核相当于、甚至超过正常巨噬细胞的胞核,或为正常淋巴细胞胞核的2倍以上。
【临床表现】
该型肿瘤在西方国家占成人非霍奇金淋巴瘤30%~40%,在发展中国家还要高,发病年龄的范围较宽,中位年龄60~70岁,但也可见于儿童;男性比女性稍多。可发生在结内和结外,原发结外的可高达40%。可发生在结外的任何部位,如皮肤、中枢神经、骨、各脏器、软组织、腮腺和Waldeyer环。原发于骨髓和/或累及到血液的情况罕见。 典型的表现是患者出现结内或结外迅速长大的肿块,可伴有症状,随着病情的发展常常扩散。
【病理变化】
淋巴结结构大部或全部被均质鱼肉状的瘤组织取代。偶尔病变仅局部生长。可出现出血坏死。结外弥漫性大B细胞淋巴瘤常形成瘤块,伴有或不伴有纤维化。典型的表现是正常的淋巴结结构或结外组织被弥漫性的淋巴组织取代。病变可累及整个或部分淋巴结,也可以仅见于滤泡间区,但累及淋巴窦不常见。淋巴结周围组织常有浸润,可见宽窄不一的硬化性纤维条带。弥漫性大B细胞淋巴瘤是由转化的大淋巴样细胞组成。该瘤在细胞形态学上有不同的变异型,但在实际工作中要准确地区分这些变异型有时存在一定难度。除少数病例外,免疫表型和遗传学参数都无助于区别形态学上的变异。
肿瘤细胞表达广泛的B细胞抗原标记物。 50%~70%的病例表达免疫球白表面和/或胞浆抗原。
弥漫性大B细胞淋巴瘤属于侵袭性淋巴瘤,但采用联合化疗有治愈的可能性。肿瘤增殖率高,则预后较差。Bcl-2、p53(+)是预后不好的指标。
【黏膜相关淋巴组织结外边缘区B细胞淋巴瘤】
黏膜相关淋巴组织结外边缘区B细胞淋巴瘤(extranodal marginalzone B-cell lymphoma of mucosa-associatedlymphoid tissue,MALT lymphoma ),是一种结外淋巴瘤。肿瘤由形态多样的小B细胞组成,其中可有边缘带(中心细胞样)细胞、单核样细胞、小淋巴细胞和散在的免疫母细胞及中心母细胞样细胞。部分病例中,可见到细胞浆细胞样分化。肿瘤细胞可位于反应性滤泡的边缘带,并可扩展到滤泡间区。当肿瘤细胞浸润上皮时,可形成典型的淋巴上皮病变。
MALT淋巴瘤占所有B细胞淋巴瘤的7%~8%,占原发性胃淋巴瘤的50%,多数为成人。大多数MALT淋巴瘤病例有慢性炎症性疾病病史,常常是自身免疫性疾病,引起结外淋巴组织增生。例如,幽门螺杆菌相关的慢性胃炎、舍格伦综合征(SjögrenS syndrome )、桥本甲状腺炎。有研究显示,患有自身免疫性疾病的患者如舍格伦综合征、桥本甲状腺炎,发生MALT淋巴瘤的危险性增加。患有舍格伦综合征和淋巴上皮性唾液腺炎的患者4%~7%发生明显的淋巴瘤,发生淋巴瘤的危险性较普通人群增加44倍。这些患者发生的淋巴瘤大约85%是MALT淋巴瘤。
【临床表现】
MALT淋巴瘤最好发的部位是胃肠道,占所有病例的50%,其中85%为胃部受累。其他较常见的部位为肺、眼附属器处、皮肤、甲状腺、乳腺、唾液腺等。绝大多数患者表现Ⅰ~Ⅱ期疾病,约20%的患者骨髓受累,但是检出率因原发部位不同有所变化。原发于胃的病例骨髓受累较少,原发在眼附属器或肺的病例骨髓受累较多。多个结外部位受累的情况可达10%。多部位淋巴结受累的情况较少见。应用结内淋巴瘤分级系统可能对MALT淋巴瘤造成误导。由于多处结外部位受累,特别是在同一器官(如腮腺、皮肤),并不能真实地反映肿瘤的扩散。
【病理变化】
瘤细胞先浸润反应性滤泡周围,然后扩展至滤泡套区,在边缘带扩散,形成融合的区域,取代部分或全部滤泡。典型的边缘带B细胞是小到中等细胞,核轻微不规则,染色质中等,核仁不明显,近似于中心细胞,胞质相对丰富、淡染。淡染的胞质增多时,可出现单核细胞样表现。另一种情况,边缘带细胞可近似于小淋巴细胞。浆细胞样分化可见大约1/3的胃MALT淋巴瘤,在甲状腺MALT淋巴瘤中浆细胞样分化更明显。在腺体组织中上皮常常受累及破坏,形成所谓的淋巴上皮病变。淋巴上皮病变是指变形或破坏的上皮内有3个以上的边缘区细胞,常伴有上皮细胞嗜碱性变。MALT淋巴瘤特指主要由小细胞组成的淋巴瘤,MALT淋巴瘤中可见少量转化的中心母细胞或免疫母细胞样的大细肥,但是当转化的大细胞形成实性或片状的区域时,应诊断为弥漫性大B细胞淋巴瘤伴有MALT淋巴瘤的表现。
MALT淋巴瘤呈CD20和CD79a(+)。瘤细胞表达边缘区细胞相关抗原CD21和CD35。现在还没有特异的标记来确定MALT淋巴瘤。在与良性淋巴细胞浸润病变鉴别时,证明轻链的单一性(克隆性)非常重要。
MALT淋巴瘤具有惰性的临床过程,缓慢扩散。多年后可复发,复发时可累及到其他部位。该瘤对放疗敏感。局部治疗后可获长期无瘤生存。结外多部位受累,甚至骨髓受累也不一定意味着预后不好。该瘤有可能发生大B细胞淋巴瘤转化。
【结外NK/T细胞淋巴瘤,鼻型】
结外NK/T细胞淋巴瘤,鼻型(extranodal NK/T-cell lymphoma ,nasal type),鼻型主要发生在结外,以血管浸润和破坏、显著坏死、表达细胞毒性分子和EBV感染为特点。该瘤曾有多种名称,如血管中心性T细胞淋巴瘤、恶性中线网状细胞增生症、多形性中线网状细胞增生症、致死性中线肉芽肿、血管中心性免疫增殖性病变。
【临床表现】
结外NK/T细胞淋巴瘤常见于成年男性。该瘤好发于鼻腔、鼻咽部、腭部、皮肤、软组织、胃肠道等。部分病例可累及到淋巴结。发生在鼻部的肿瘤,患者表现鼻阻、鼻出血,这是由于肿块及其所造成的中面部结构破坏所致(所谓的致死性中肉芽肿)。肿瘤可侵及周围相邻组织如鼻咽部、副鼻窦、眼眶、口腔、腭部和口咽部。肿瘤最初常常局限于上呼吸道,很少累及骨髓,但很快扩散到不同部位,如皮肤、胃肠逍、颈部淋巴结。发生在鼻腔外的鼻型NK/T细胞淋巴瘤依不同累及部位各有不同的表现。
【病理变化】
各种部位的结外NK/T细肥淋巴瘤的形态基本相似。发生黏膜部位的常有溃疡形成。瘤细胞呈弥散性浸润,并以血管中心浸润和血管破坏现象常见。凝固性坏死和凋亡小体很常见,这是由于瘤细胞造成血管梗阻所致。
结外NK/T细胞淋巴瘤细胞形态很广泛。细胞可能是小、中、大或间变细胞。多数病例为中等细胞或大小混合细胞。胞核可不规则或变长。染色质呈颗粒状,但很大的细胞核呈泡状。通常核仁不明显或有小核仁。胞质中等,淡染至透亮,核分裂象易见,即使在小细胞为主的病例也是如此。
NK/T细胞淋巴瘤,特别是小细胞和混合细胞为主的淋巴瘤,可见大量反应性炎性细胞,如淋巴细胞、浆细胞、组织细胞、嗜酸性粒细胞(因此,曾称多形性中线网状细胞增生症)。这些病例很像炎性疾病。这种淋巴瘤有时件有假上皮瘤增生,类似于鳞癌。
最典型的免疫表型是CD2和CD56(+),多数病例也表达细胞毒性颗粒相关蛋白。其他T细胞和NK细胞相关抗原呈(-)。
NK/T细胞淋巴瘤,鼻型的预后情况变化较大,部分患者对治疗反应较好,而其余的病例即使使用了高强度化疗效果也不好,患者多死于肿瘤扩散。发生在鼻腔外的NK/T细胞淋巴瘤,鼻型具有高度侵袭性,对治疗反应差,存活时间短。多种耐药基因表达是多数病例预后差的原因。
【Burkitt淋巴瘤】
 Burkitt淋巴瘤是一种倍增生时间特别短的B细胞的淋巴瘤,好于结外或以急性白血病形式出现,肿瘤由单一、中等大小的转化B细胞组成。Burkitt淋巴瘤可分为3种临床变异型,即地方性、散发性和免疫缺陷相关性Burkitt淋巴瘤,每一型都具有不同的临床表现、形态学和生物学特点。结外是最常受累及的部位,3种临床变异型均可累及中枢神经。
Burkitt淋巴瘤是一种倍增生时间特别短的B细胞的淋巴瘤,好于结外或以急性白血病形式出现,肿瘤由单一、中等大小的转化B细胞组成。Burkitt淋巴瘤可分为3种临床变异型,即地方性、散发性和免疫缺陷相关性Burkitt淋巴瘤,每一型都具有不同的临床表现、形态学和生物学特点。结外是最常受累及的部位,3种临床变异型均可累及中枢神经。
【临床表现】
地方性Burkitt淋巴瘤发生在中非一带,是该地区儿童最常见的恶性肿瘤,发病高峰为3~8岁,男女之比为2∶1。该型50%累及颌骨和面部骨(眼眶)。散发性Burkitt淋巴瘤见于世界各地,主要发生在儿童和青年,发病率低,且不常累及颌骨。免疫缺陷相关性Burkitt淋巴瘤与HIV感染有关,多发生在AIDS患者。此型病例的25%~40%有EBV感染,该型淋巴瘤常累及淋巴结和骨髓。颌骨病损发生于颌骨后部,常累及所有四个象限。上颌较下颌多见。肿瘤快速生长可形成较大包块而使面部变形。上颌肿瘤可扩展至鼻窦、鼻腔和眼眶。受累牙可松动、移位或脱落。X线照片可表现为虫蛀状,边缘不清。骨皮质穿破后可累及软组织。
【病理变化】
病变部位表现为肿块,瘤组织呈鱼肉状、伴出血坏死。经典Burkitt淋巴瘤,细胞单型一,中等大小,弥漫浸润。固定后细胞有时呈铺路石或镶嵌样排列。核圆形、染色质粗,副染色质相对清晰,核中等大小、居中,嗜碱性。胞质深嗜碱、常伴有脂质空泡。肿瘤核分裂多见、增殖率很高,并且细胞自发牲死亡率高(凋亡)。“星空”现象常见,这是巨噬细胞吞噬凋亡的肿瘤细胞所致。肿瘤细胞核的大小近似于“星空”中的组织细胞核。
浆细胞样分化Burkitt淋巴瘤,细胞核偏位、单个中位核仁。胞质嗜碱性,含单一的大小和形态呈多形性,类似于非典型Burkitt淋巴瘤/Burkitt淋巴瘤样变异型。该型可见于儿童,但多见于免疫缺陷的患者。非典型Burkitt淋巴瘤/Burkitt淋巴瘤样变异型,主要由中等大Burkitt淋巴瘤细胞组成,并表现出大量的细胞凋亡和很高的核分裂指数。该型的细胞大小、形态有明显的多形性。核仁不明显、数量不多。
肿瘤细胞表达B细胞相关抗原,但CD5、CD23、TdT呈阴性。不表达Bcl-2,因此,有助于鉴别滤泡型淋巴瘤和滤泡的反应性增殖。
地方性和散发性Burkitt淋巴瘤都具有高度侵袭性,但也具有潜在的可治愈性。地方性Burkitt淋巴瘤对化疗高度敏感。高强度的联合化疗可使分期低的病例治疗率达到90%,进展期(晚期)病例达到60%~80%。对儿童的治疗效果好于成人。复发常发生在诊断后一年内。患者2年不复发可视为治愈。然而,也可见少数患者发生第二个Burkitt淋巴瘤的情况。

口腔转移性肿瘤(metastatic tumors in the oraltissues)为原发于身体他处的肿瘤转移至颌骨或口腔软组织,但不常见。值得注意的是口腔转移性肿瘤约23%首先在口腔发现转移瘤,而未发现原发瘤。
附着龈是口腔软组织转移性肿瘤最常见的部位,其次是舌,其他处很少见。性别不同口腔转移性肿瘤其原发部位不同,男性分别是肺、肾、肝、前列腺;女性则分别为乳腺、生殖器、肾、结肠/直肠。转移率与性别及转移部位有关,如:男性肺肿瘤转移是口腔转移性肿瘤中最多见,约占31.3%;肾肿瘤转移占14%。女性乳腺肿瘤转移占24.3%。肾上腺及生殖器来源肿瘤占14.8%。
口腔转移性肿瘤的临床表现与转移部位有关。牙龈转移灶早期表现类似于牙龈增生性或反应性病变,如化脓性肉芽肿、外周性巨细胞肉芽肿和纤维性龈瘤等。由于口腔转移性肿瘤较少见而且有些临床上容易与良性疾病相混淆,给临床医生诊断带来很大困难。组织病理学上,某些原发于口腔的恶性肿瘤(如涎腺导管癌、涎腺透明细胞癌、原发性口腔鳞状细胞癌)与一些转移癌(转移性乳腺癌、肾癌、来源于其他器官的鳞状细胞癌,如肺癌)很难鉴别。因此,对病理诊断也是很大的挑战。临床上,若发现病变的临床表现是少见的或患者有明确的全身性肿瘤者,必须进行口腔病灶的活检。免疫学染色与组织病理学特点、病史及影像学检查相结合,有助于口腔转移性肿瘤的明确诊断。
-----------------------------------------------------------------------------------------



